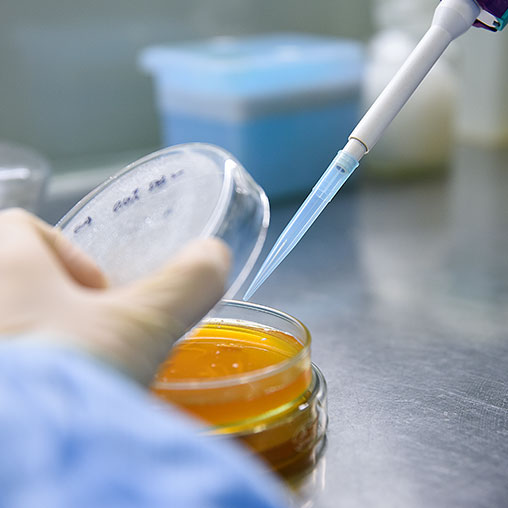

We have been committed to providing high-quality products and professional services to our customers in feed, food, cosmetics, medicine and other fields, thus to contribute to the development of animal nutrition and human health. Our products include vitamin K3, vitamin B1, nicotinamide, niacin, vitamin B5 and alanine.

We have been specialized in providing personalized solutions for customers in the leather and fur industry, and committed to becoming a global supplier of high-quality leather chemicals and promoting the sustainable development of the leather industry. Our products cover a full range of leather chemicals, including chrome tanning agents, retanning agents, fatliquors, additives, etc.

We have been committed to contributing to human health in the field of medical diagnosis and treatment. Our active pharmaceutical ingredients (APIs) products and businesses include contrast agent APIs and intermediates, topiroxostat and its intermediates, as well as the custom-made processing of APIs and intermediates. Our preparation products involve the endocrine and metabolism, nerves, respiratory and other therapeutic areas.

We have been specialized in providing key components and solutions for customers in the food, daily chemical and other industries, and committed to becoming a leading player in the global subdivision. Our products and services include vanillin, ethyl vanillin and other synthetic fragrances.
We have been committed to contributing to clean and green resource utilization and environmental protection. Our products and services include the production and OEM of various kinds of molecular sieves and catalysts.

Through the acquisition of Lanxess CISA, we have established complete international supply chain and industrial chain, thus to ensure to provide industrial-leading products and services for global customers in a continuous and stable manner. Our products mainly include sodium dichromate (SDC), chromic acid (CA) and chrome tanning agent (CTS).